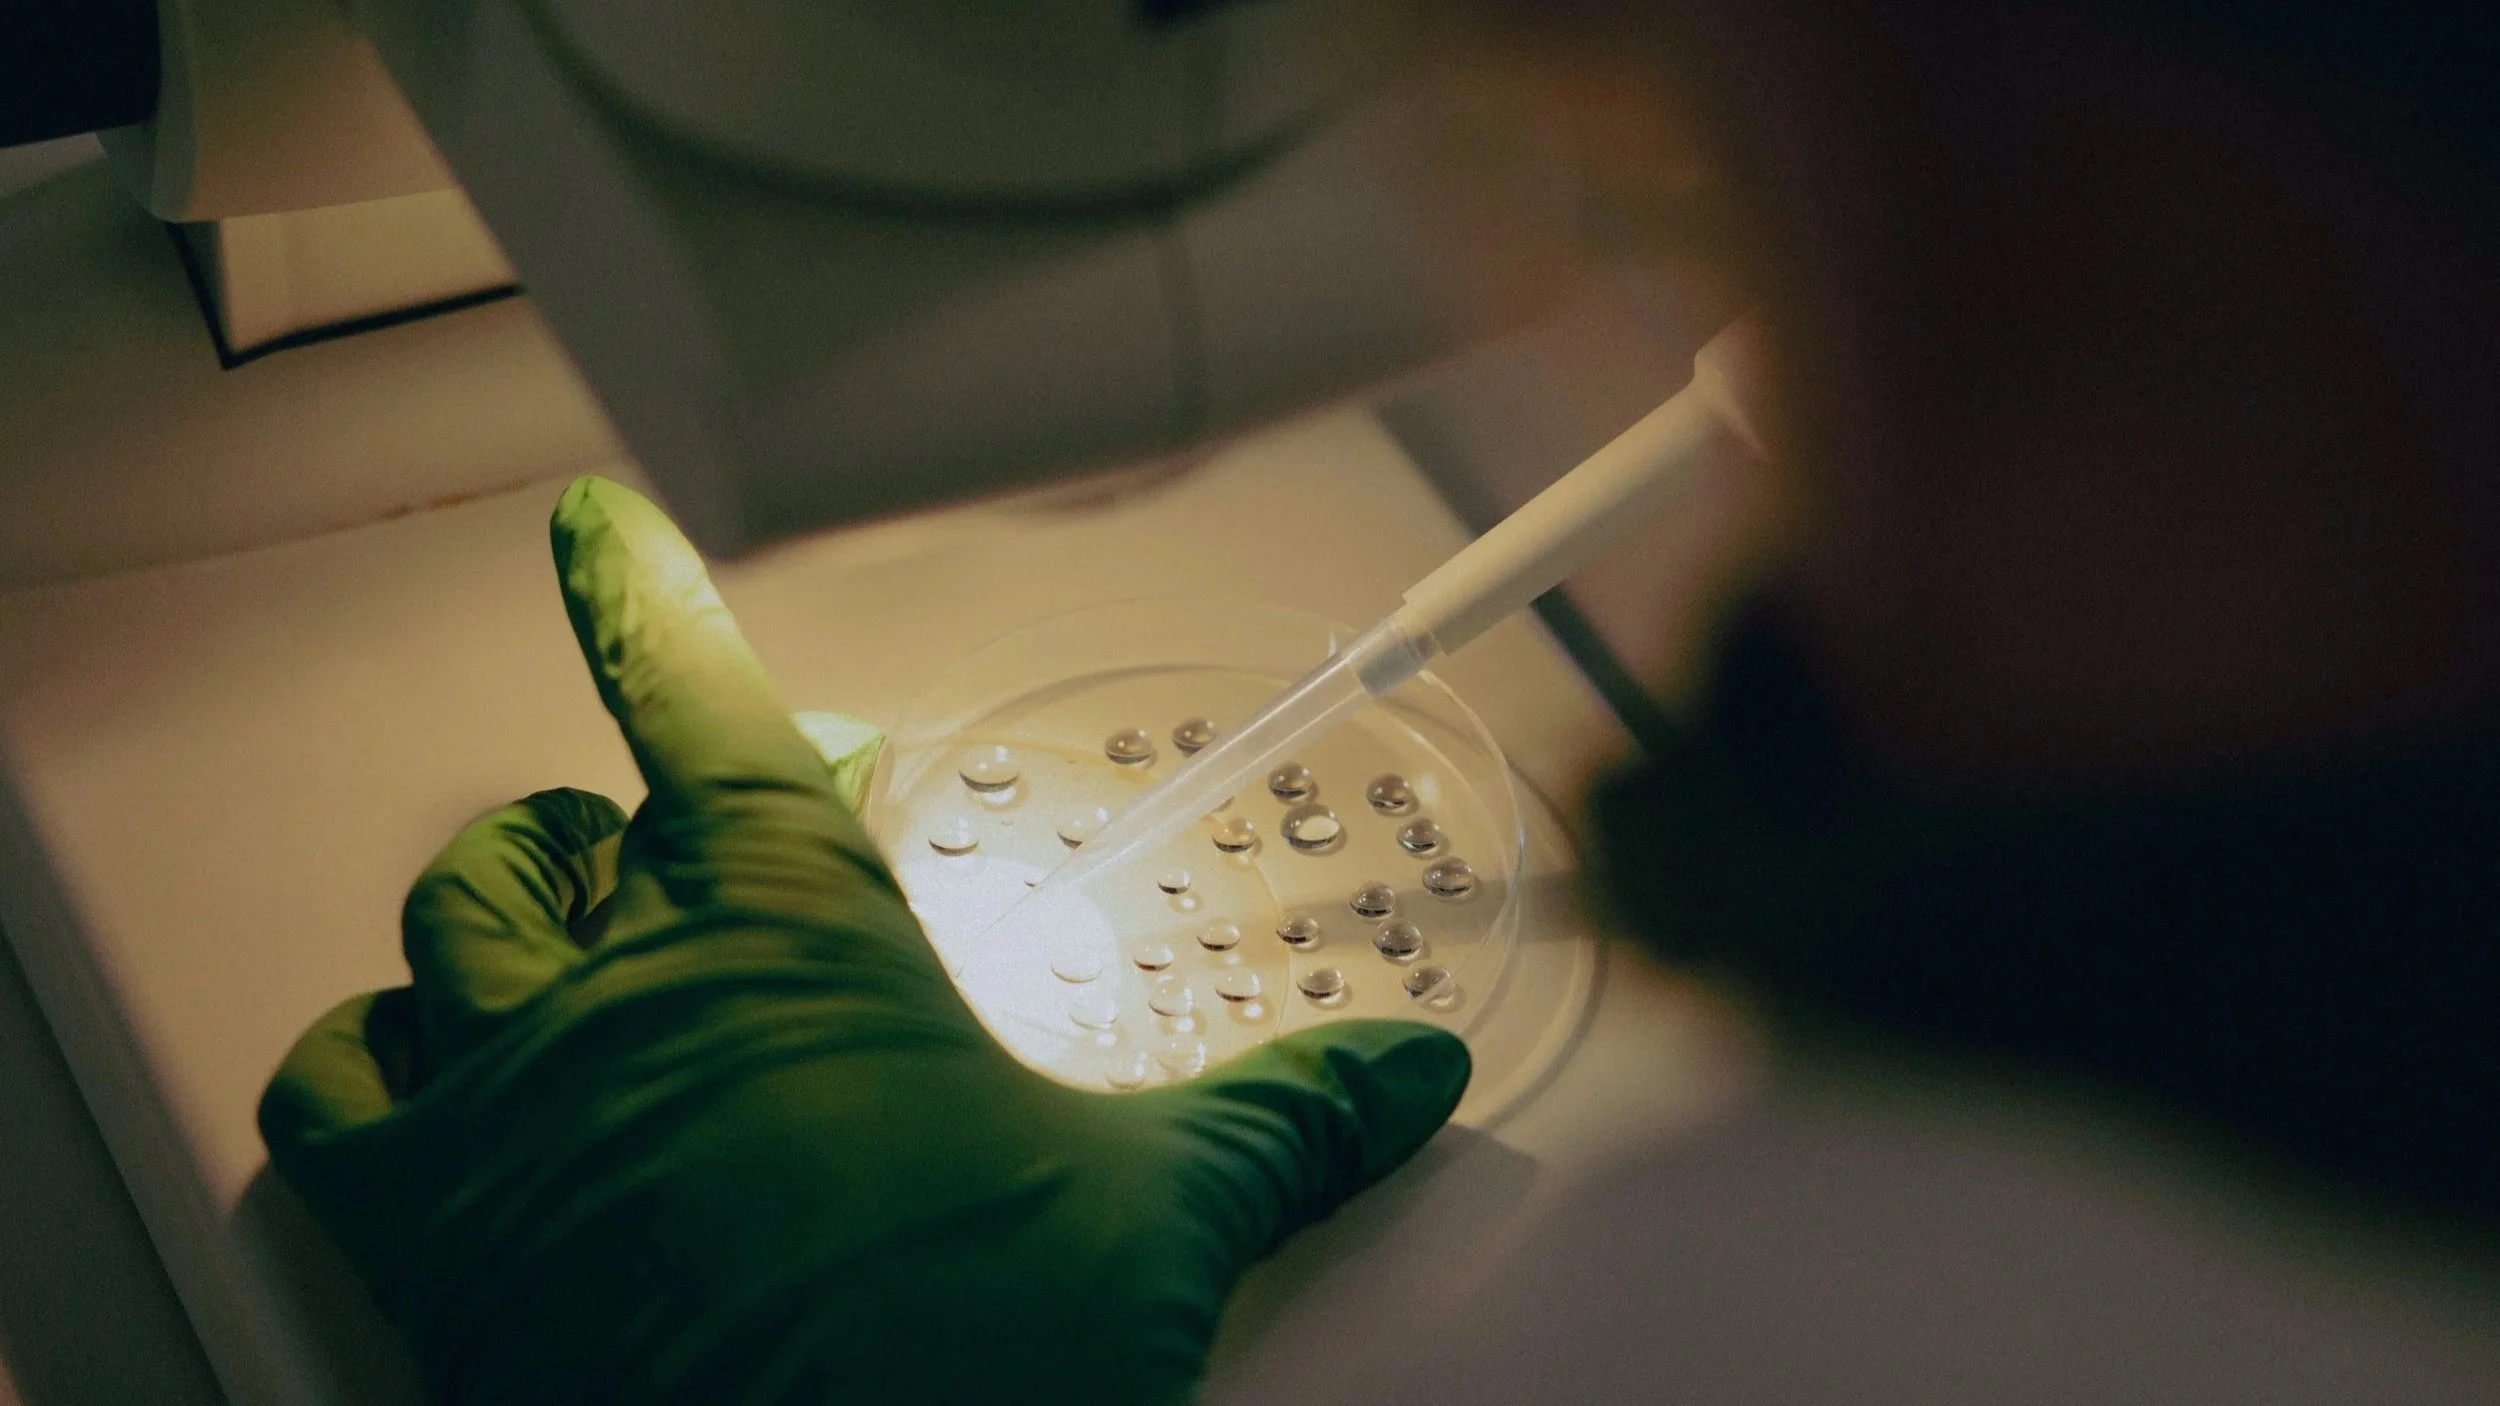

The Cultivation
Sea Forest’s operations are located in Triabunna & Swansea, Tasmania. It’s here, in the lab and hatchery where our Sea Forest team developed the world-leading SeaFeed™ supplement. Based on the science of seaweed.
Sea Forest is now producing more SeaFeed™ than ever, and as our production operations continue to grow, so too will our positive impact on the planet.